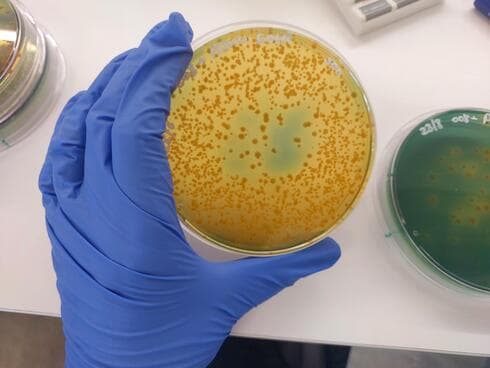
צילום: אוניברסיטת תל אביב

מנגנון הפעולה של חיידק, שגורם למחלה קטלנית באלמוגים, נחשף במחקר שערכו חוקרים מהפקולטה למדעי הרפואה והבריאות באוניברסיטת תל אביב. המנגנון, המשלב שתי מערכות להזרקת רעלנים, מופעל כשטמפרטורת המים עולה מעל 23 מעלות צלסיוס, אז החיידק הופך אלים. החוקרים אמרו: "הבנת המנגנונים שמובילים למחלה עשויה לעזור לנו להגן על שוניות האלמוגים שנעלמות במהירות בכל רחבי העולם".
את המחקר הובילו פרופ' דור סלומון ותלמידת המחקר שיר מאס, בשיתוף פרופ' מוטי גרליץ. כמו כן השתתפו חוקרים ממכללת בראודה להנדסה בכרמיאל, ומאוניברסיטת אינדיאנה ואוניברסיטת צפון קרוליינה בארה"ב. המאמר פורסם בכתב העת PLOS Biology.
פרופ' סלומון הסביר על חשיבות השוניות: "לשוניות אלמוגים יש מגוון תפקידים חשובים בעולמנו. מבחינה אקולוגית הן מהוות בית גידול עבור יצורים ימיים רבים, ובהיבט הכלכלי הן משמשות בסיס לענפים כמו תיירות ודיג. בנוסף הן מגינות על חופים מפני סופות גדולות כמו הוריקנים".
על הפגיעה בהן, הוא הוסיף: "בעשורים האחרונים אנו מאבדים שוניות בכל העולם, כתוצאה מהתחממות מי הים וזיהומים שיוצר האדם, וגם בשל עלייה במחלות שנגרמות על ידי מיקרו-אורגניזמים. מחקרים מצאו כי לעלייה בתדירות ובתפוצת המחלות יש קשר ישיר לעלייה בטמפרטורת המים. חיידקים מסוימים, שאינם מסוכנים בטמפרטורות נמוכות יותר, הופכים למחוללי מחלות, חלקן קטלניות, כשהמים מתחממים".
שיר מאס התייחסה גם היא למחקר: "אחד ממחוללי המחלות העיקריים באלמוגים הוא החיידק Vibrio coralliilyticus - שאופיין לראשונה בתחילת שנות ה-2000 על ידי מעבדתו של פרופ' יוג'ין רוזנברג, בפקולטה למדעי החיים באוניברסיטת תל אביב. חיידק זה שייך למשפחה רחבה של חיידקים, שחלקם גורמים למחלות מעיים כמו כולרה. גם באלמוגים מדובר למעשה במחלת מעיים (לאלמוגים יש מעיים. פוליפ של אלמוג מורכב מזרועות שלוכדות מזון וממעיים שמעכלים אותו)".
מאס הוסיפה: "מחקרי עבר העלו שכאשר טמפרטורת מי הים מגיעה ל-23 מעלות צלסיוס, החיידק הופך למחולל מחלה באלמוגים ובבעלי חיים ימיים נוספים. כמו כן ידוע שחלק מזני החיידק הופכים קטלניים עוד יותר בטמפרטורת מים גבוהה מ-27 מעלות. התופעה מוכרת כבר שנים רבות, אך המנגנון באמצעותו תוקף החיידק את האלמוג לא היה ידוע עד כה. במחקר שלנו ביקשנו לחשוף את המנגנון המולקולרי של המחלה".
בשלב הראשון בחנו החוקרים ריצופי גנום רבים של החיידק, מתוך מאגרי אינטרנט קיימים, בחיפוש אחר מערכות להזרקת רעלנים – תחום המומחיות של מעבדתו של פרופ' סלומון. בכל הזנים של Vibrio coralliilyticus נמצאו שתי מערכות להפרשת רעלנים, וניסויי מעבדה העלו כי שתיהן מבטאות ומפרישות חלבונים בדיוק בטווח הטמפרטורות שבו החיידק הופך למחולל מחלה. בניסויים הבאים בדקו החוקרים את אופן הפעולה של שתי המערכות.
פרופ' סלומון אמר: "מצאנו שמערכת מספר 1 תוקפת והורגת מספר רב של חיידקים אחרים. זוהי אסטרטגיה נפוצה, שבאמצעותה מבקש חיידק תוקף לפנות לעצמו מקום ולהשתלט על המאחסן. נעזרנו בשיטות ביוכימיות כדי לזהות את הרעלנים, ומצאנו שהם דומים ברובם לרעלנים אנטי-בקטריאליים מוכרים, המופרשים גם על ידי חיידקים אחרים. מערכת מספר 2, לעומת זאת, תוקפת ישירות את תאי בעל החיים המאחסן - פעילות פחות שכיחה במערכות הפרשת רעלנים מסוג זה. בניסויים שלנו הרגה מערכת זו סוג של סרטן ימי זעיר הקרוי ארטמיה ששימש כמערכת מודל, וכן תאים של עכבר, אך לא גרמה כל נזק לחיידקים אחרים".
כשהחוקרים ביקשו לזהות את הרעלנים במערכת 2 חיכתה להם הפתעה: הם מצאו תשעה רעלנים חדשים, שכלל לא היו מוכרים בהקשר של מערכות מסוג זה בחיידקים, ושבעה מהם הופיעו בכל הגנומים שרוצפו.
החוקרים משערים כי ממצאי המחקר מעידים על אסטרטגיה משולבת ואפקטיבית במיוחד של החיידק Vibrio coralliilyticus, שגורמת נזק רב לשוניות אלמוגים. החיידק מצויד בשתי מערכות להזרקת רעלנים: אחת מהן הורגת את המתחרים - החיידקים "הטובים" שמגינים על המעיים של האלמוג, ומפנה את הדרך למערכת השנייה שתוקפת ישירות את תאי האלמוג. שתי מערכות ההזרקה מופעלות בדיוק בתנאים הסביבתיים שבהם פורצת המחלה: טמפרטורת מים מעל 23 מעלות צלסיוס.
פרופ' סלומון סיכם: "במחקר זה פענחנו את המנגנון באמצעותו גורם החיידק Vibrio coralliilyticus למחלה קשה ואף למוות בבעלי חיים ימיים, ביניהם אלמוגים. ככלל, הבנת מנגנון מחולל מחלה יכולה לסייע במניעתה. כבר היום מפתחים חוקרים בעולם פרוביוטיקה לאלמוגים, שנועדה לחזק אותם מול חיידקים מחוללי מחלות, וטיפולים אלה נמצאו יעילים בניסויים מבוקרים. מעבר לכך, התובנות שלנו עשויות לסייע גם בהתמודדות מול חיידקים אחרים שמשתמשים במנגנונים דומים, ובכך לתרום תרומה חשובה לתחומים שונים, מאקולוגיה ועד לחקלאות ורפואה".